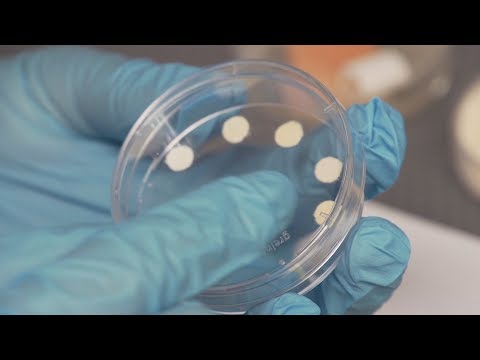
featured

shnickerman (25)
11 followers16 postsNot following anybody1 HP
Blacklisted UsersMuted UsersFollowed BlacklistsFollowed Muted Lists
Blacklisted UsersMuted UsersFollowed BlacklistsFollowed Muted Lists
Joined September 2017 Active 8 years ago